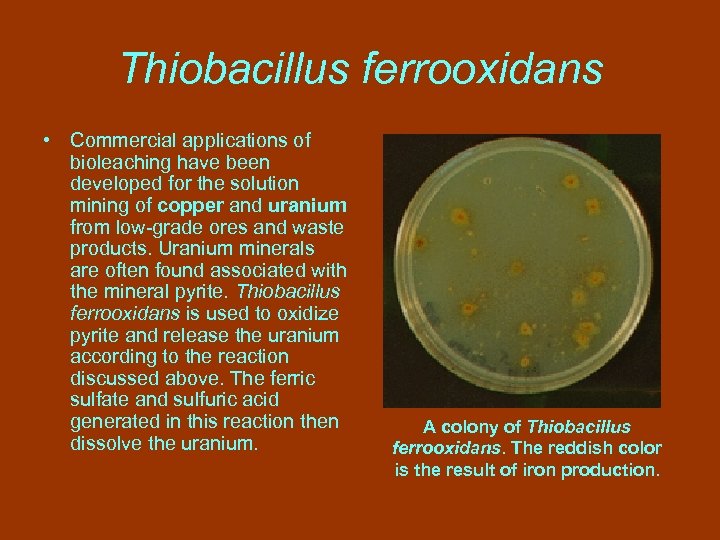
Thiobacillus ferrooxidans • Commercial applications of bioleaching have been developed for the solution mining

b6464c79553b1e122346ae36ae6ba3bd.ppt
- Количество слайдов: 134
 Ю. Посудін. Моніторинг довкілля з основами метрології Лекція 19 РЕМЕДІАЦІЯ НАВКОЛИШНЬОГО СЕРЕДОВИЩА ТА НАНОТЕХНОЛОГІЯ Yuriy Posudin Environmental Monitoring with Fundamentals of Metrology Lecture 19 ENVIRONMENTAL REMEDIATION AND NANOTECHNOLOGY
Ю. Посудін. Моніторинг довкілля з основами метрології Лекція 19 РЕМЕДІАЦІЯ НАВКОЛИШНЬОГО СЕРЕДОВИЩА ТА НАНОТЕХНОЛОГІЯ Yuriy Posudin Environmental Monitoring with Fundamentals of Metrology Lecture 19 ENVIRONMENTAL REMEDIATION AND NANOTECHNOLOGY
 НАНОТЕХНОЛОГІЯ • Нанотехнологія міждисциплінарна галузь фундаментальної та прикладної науки і техніки, яка має справу з вивченням та маніпулюванням окремими атомами та молекулами.
НАНОТЕХНОЛОГІЯ • Нанотехнологія міждисциплінарна галузь фундаментальної та прикладної науки і техніки, яка має справу з вивченням та маніпулюванням окремими атомами та молекулами.
 Наночастинки та наноматеріали Об’єктами нанотехнології є наночастинки – дрібні тіла, що поводять себе як окремі одиниці з точки зору їх властивостей і транспортування, та розміри яких становлять 1– 100 нм, а також наноматеріали, розроблені на основі наночастинок з унікальними характеристиками, обумовлені мікроскопічними розмірами їх складових.
Наночастинки та наноматеріали Об’єктами нанотехнології є наночастинки – дрібні тіла, що поводять себе як окремі одиниці з точки зору їх властивостей і транспортування, та розміри яких становлять 1– 100 нм, а також наноматеріали, розроблені на основі наночастинок з унікальними характеристиками, обумовлені мікроскопічними розмірами їх складових.
 1 нм = 10 -9 м • Префікс “нано” походить від грецького слова нанос (карлик), що означає 10 -9 чого-небудь. • Для порівняння типова довжина подвійного зв’язку між атомами вуглецю у молекулі становить 0, 12 -0, 15 нм. • Діаметр подвійної спіралі ДНК дорівнює близько 2 нм.
1 нм = 10 -9 м • Префікс “нано” походить від грецького слова нанос (карлик), що означає 10 -9 чого-небудь. • Для порівняння типова довжина подвійного зв’язку між атомами вуглецю у молекулі становить 0, 12 -0, 15 нм. • Діаметр подвійної спіралі ДНК дорівнює близько 2 нм.
 Нанорозміри • Поодинока людська волосина має товщину близько 80000 нанометрів. Нанопровідник, скручений у кільце, на тлі людської волосини (Mazur Group, 2008)
Нанорозміри • Поодинока людська волосина має товщину близько 80000 нанометрів. Нанопровідник, скручений у кільце, на тлі людської волосини (Mazur Group, 2008)
 Richard Feynman • Річарду Фейнману, американському фізикутеоретику, належить перше згадування щодо методів, які пізніше назвуть нанотехнологією (1959). • Він припустив, що можливо окремо, механічно переміщувати атоми за допомогою маніпулятора відповідних розмірів. • (“There’s Plenty of Room at the Bottom”, a talk given by physicist at an American Physical Society meeting on December 29, 1959).
Richard Feynman • Річарду Фейнману, американському фізикутеоретику, належить перше згадування щодо методів, які пізніше назвуть нанотехнологією (1959). • Він припустив, що можливо окремо, механічно переміщувати атоми за допомогою маніпулятора відповідних розмірів. • (“There’s Plenty of Room at the Bottom”, a talk given by physicist at an American Physical Society meeting on December 29, 1959).
 Norio Taniguchi • Японський вчений Норіо Танігуті вперше використав у 1974 році термін “нанотехнологія”, яким назвав виробництво виробів розмірами порядку нанометрів: • "'Nano-technology' mainly consists of the processing of, separation, consolidation, and deformation of materials by one atom or by one molecule. "
Norio Taniguchi • Японський вчений Норіо Танігуті вперше використав у 1974 році термін “нанотехнологія”, яким назвав виробництво виробів розмірами порядку нанометрів: • "'Nano-technology' mainly consists of the processing of, separation, consolidation, and deformation of materials by one atom or by one molecule. "
 Нанотехнологія • Нанотехнологія вивчає та контролює об’єкти розмірами 1 -100 нанометрів, особливості яких передбачають нові застосування.
Нанотехнологія • Нанотехнологія вивчає та контролює об’єкти розмірами 1 -100 нанометрів, особливості яких передбачають нові застосування.
 Відношення площі частинок S до їх об’єму V Особливою рисою наночастинок є суттєво більше порівняно з макрочастинками відношення площі частинок S до їх об’єму V. • S = 4πR 2 • V = 4/3(πR 3) • R = 1 мм: S/V = 3· 103 • R = 1 мкм S/V = 3· 106 • R = 1 нм: S/V = 3· 109 Це характеризує високу реактивну здатність наночастинок та їх більш високий контакт з забруднювачами.
Відношення площі частинок S до їх об’єму V Особливою рисою наночастинок є суттєво більше порівняно з макрочастинками відношення площі частинок S до їх об’єму V. • S = 4πR 2 • V = 4/3(πR 3) • R = 1 мм: S/V = 3· 103 • R = 1 мкм S/V = 3· 106 • R = 1 нм: S/V = 3· 109 Це характеризує високу реактивну здатність наночастинок та їх більш високий контакт з забруднювачами.
 Як одержати наночастинки? • 1. З компактних матеріалів того ж (чи іншого) складу шляхом диспергування різними методами. • 2. З хімічних сполук шляхом направленої зміни їх складу з подальшим припиненням росту нової фази на стадії нанорозмірів. • Найбільш вірогідною кінетичною закономірністю формування наночастинок є сполучення високої швидкості зародження кристалічної фази з малою швидкістю її росту.
Як одержати наночастинки? • 1. З компактних матеріалів того ж (чи іншого) складу шляхом диспергування різними методами. • 2. З хімічних сполук шляхом направленої зміни їх складу з подальшим припиненням росту нової фази на стадії нанорозмірів. • Найбільш вірогідною кінетичною закономірністю формування наночастинок є сполучення високої швидкості зародження кристалічної фази з малою швидкістю її росту.
 Залізо • Залізо — блискучий сріблясто-білий важкий метал, який легко окислюється в атмосферних умовах, утворюючи оксиди феруму. • Масова частка феруму в земній корі становить 5 %. Він займає четверте місце за розповсюдженістю в природі. Найважливішими залізними рудами є: магнетит Fе 3 О 4, гематит Fe 2 О 3, лімоніт – Fe 2 O 3·n. H 2 O, сидерит Fе. СО 3, пірит Fе. S 2.
Залізо • Залізо — блискучий сріблясто-білий важкий метал, який легко окислюється в атмосферних умовах, утворюючи оксиди феруму. • Масова частка феруму в земній корі становить 5 %. Він займає четверте місце за розповсюдженістю в природі. Найважливішими залізними рудами є: магнетит Fе 3 О 4, гематит Fe 2 О 3, лімоніт – Fe 2 O 3·n. H 2 O, сидерит Fе. СО 3, пірит Fе. S 2.
 Залізо нульової валентності Nanoscale zero-valent iron (n. ZVI) Метали нульової валентності, зокрема залізо нульової валентності (n. ZVI), мають надзвичайну поверхневу реактивність та використовуються у ремедіації ґрунтів, седиментів та ґрунтових вод.
Залізо нульової валентності Nanoscale zero-valent iron (n. ZVI) Метали нульової валентності, зокрема залізо нульової валентності (n. ZVI), мають надзвичайну поверхневу реактивність та використовуються у ремедіації ґрунтів, седиментів та ґрунтових вод.
 Залізо нульової валентності (n. ZVI) • Елементарне залізо діє як електронний донор, тоді як забруднюючі речовини виконують функції акцепторів електронів.
Залізо нульової валентності (n. ZVI) • Елементарне залізо діє як електронний донор, тоді як забруднюючі речовини виконують функції акцепторів електронів.
 Електронна конфігурація атома феруму • 1 s 2 2 s 2 p 6 3 s 2 p 6 d 6 4 s 2 Електронна конфігурація: • На зовнішньому енергетичному рівні атома феруму знаходиться два s -електрони, а на передзовнішньому енергетичному рівні відбувається заповнення d-підрівня. • У своїх сполуках залізо проявляє ступені окиснення +2 та +3.
Електронна конфігурація атома феруму • 1 s 2 2 s 2 p 6 3 s 2 p 6 d 6 4 s 2 Електронна конфігурація: • На зовнішньому енергетичному рівні атома феруму знаходиться два s -електрони, а на передзовнішньому енергетичному рівні відбувається заповнення d-підрівня. • У своїх сполуках залізо проявляє ступені окиснення +2 та +3.
 Чисте залізо
Чисте залізо
 Чисте залізо Колона, що містить 98 % заліза у Делі, Індія, простояла майже 1600 років не зазнавши корозії.
Чисте залізо Колона, що містить 98 % заліза у Делі, Індія, простояла майже 1600 років не зазнавши корозії.
 Залізо нульової валентності • Особливу увагу упродовж останніх років привернуло залізо нульової валентності (Zero-Valent Iron, ZVI або Fe 0) завдяки своїй здатності відновлювати різноманітні забруднювачі, у тому числі дехлорувати хлоровмісні розчинники, відновляти нітрати до атмосферного азоту, іммобілізувати численні неорганічні іони.
Залізо нульової валентності • Особливу увагу упродовж останніх років привернуло залізо нульової валентності (Zero-Valent Iron, ZVI або Fe 0) завдяки своїй здатності відновлювати різноманітні забруднювачі, у тому числі дехлорувати хлоровмісні розчинники, відновляти нітрати до атмосферного азоту, іммобілізувати численні неорганічні іони.
 Залізо нульової валентності За аеробними умовами (у присутності кисню) Fe 0 реагує з розчиненим киснем, утворюючи іони Fe 2+ та воду (Matheson and Tratnyek 1994): 2 Fe 0 + 4 H+ + O 2 → 2 Fe 2+ + 2 H 2 O.
Залізо нульової валентності За аеробними умовами (у присутності кисню) Fe 0 реагує з розчиненим киснем, утворюючи іони Fe 2+ та воду (Matheson and Tratnyek 1994): 2 Fe 0 + 4 H+ + O 2 → 2 Fe 2+ + 2 H 2 O.
 Залізо нульової валентності Крім того, Fe 0 може реагувати з водою, утворюючи іони Fe 2+, водень та іони гідроксилу ОН– (Matheson and Tratnyek 1994): 2 Fe 0 + 2 H 2 O → 2 Fe 2+ + H 2 + 2 OH–.
Залізо нульової валентності Крім того, Fe 0 може реагувати з водою, утворюючи іони Fe 2+, водень та іони гідроксилу ОН– (Matheson and Tratnyek 1994): 2 Fe 0 + 2 H 2 O → 2 Fe 2+ + H 2 + 2 OH–.
 Залізо нульової валентності • Якщо у середовищі присутня забруднююча речовина (хлорований вуглеводень), то відбувається реакція, що супроводжується приєднанням електронів до забруднюючої речовини та її відновленням, тобто дехлоруванням: RCl + H+ + 2 e– → RH + Cl–. Залізо нульової валентності звільнює електрони, які приєднуються до хлорованого вуглеводню: RCl + Fe 0 + H+ → RH + Fe 2+ + Cl–.
Залізо нульової валентності • Якщо у середовищі присутня забруднююча речовина (хлорований вуглеводень), то відбувається реакція, що супроводжується приєднанням електронів до забруднюючої речовини та її відновленням, тобто дехлоруванням: RCl + H+ + 2 e– → RH + Cl–. Залізо нульової валентності звільнює електрони, які приєднуються до хлорованого вуглеводню: RCl + Fe 0 + H+ → RH + Fe 2+ + Cl–.
 Залізо нульової валентності Отже, у присутності окислювального агента (розчиненого кисню чи води) Fe 0 окислюється до Fe 2+, що супроводжується звільненням двох електронів: Fe 0 → Fe 2+ + 2 е–.
Залізо нульової валентності Отже, у присутності окислювального агента (розчиненого кисню чи води) Fe 0 окислюється до Fe 2+, що супроводжується звільненням двох електронів: Fe 0 → Fe 2+ + 2 е–.
 Reactions of iron nanoparticles (5 g/L) with a mixture of chlorinated aliphatic hydrocarbons. Gas chromatograms are shown in this figure. Six compounds with initial concentration at 10 mg/L are presented: Trans-dichloroethene (t-DCE), cis -dichloroethene (c-DCE), 1, 1, 1 - trichloroethane (1, 1, 1 -TCA), tetrachloroethylene (PCE), trichloroethylene (TCE), and tetrachloromethane (Li et al. , 2006).
Reactions of iron nanoparticles (5 g/L) with a mixture of chlorinated aliphatic hydrocarbons. Gas chromatograms are shown in this figure. Six compounds with initial concentration at 10 mg/L are presented: Trans-dichloroethene (t-DCE), cis -dichloroethene (c-DCE), 1, 1, 1 - trichloroethane (1, 1, 1 -TCA), tetrachloroethylene (PCE), trichloroethylene (TCE), and tetrachloromethane (Li et al. , 2006).
 Залізо нульової валентності
Залізо нульової валентності
 Залізо нульової валентності
Залізо нульової валентності
 Залізо нульової валентності
Залізо нульової валентності
 Окисно-відновний потенціал • Окисно-відновний потенціал – міра здатності хімічної речовини приєднувати електрони (відновлюватися)
Окисно-відновний потенціал • Окисно-відновний потенціал – міра здатності хімічної речовини приєднувати електрони (відновлюватися)
 Окисно-відновний потенціал
Окисно-відновний потенціал
 Окисно-відновний потенціал • Сорбція має місце, якщо металеві катіони мають ОВП більш негативний, ніж у Fe (Ba 2+, Zn 2+, Cd 2+). • Якщо ОВП металевих катіонів трохи більш позитивний, ніж у Fе, то відбувається сорбція+відновлення (Ni 2+, Pb 2+). • Відновлення відбувається, якщо ОВП металевих іонів значно вищий, ніж у Fe (Cu+, Ag+).
Окисно-відновний потенціал • Сорбція має місце, якщо металеві катіони мають ОВП більш негативний, ніж у Fe (Ba 2+, Zn 2+, Cd 2+). • Якщо ОВП металевих катіонів трохи більш позитивний, ніж у Fе, то відбувається сорбція+відновлення (Ni 2+, Pb 2+). • Відновлення відбувається, якщо ОВП металевих іонів значно вищий, ніж у Fe (Cu+, Ag+).
 Залізо нульової валентності
Залізо нульової валентності
 Наночастинки заліза нульової валетності Zhang et al. (1998) at Lehigh Universuty • Активна поверхня наночастинок заліза нульової валентності становила 33, 5 м 2/г порівняно з поверхнею 0, 9 м 2/г, притаманної мікроскопічним частинкам; • Швидкість реакції наночастинок у 100 разів перевищує швидкість реакції мікрочастинок. • Польові випробування: 1, 7 кг n. ZVI було інжектовано у 14 м 3 зону забруднення ґрунтових вод трихлороетиленом. • Ефективність відновлення трихлороетилену досягала 96% упродовж 4 -тижневого моніторингу.
Наночастинки заліза нульової валетності Zhang et al. (1998) at Lehigh Universuty • Активна поверхня наночастинок заліза нульової валентності становила 33, 5 м 2/г порівняно з поверхнею 0, 9 м 2/г, притаманної мікроскопічним частинкам; • Швидкість реакції наночастинок у 100 разів перевищує швидкість реакції мікрочастинок. • Польові випробування: 1, 7 кг n. ZVI було інжектовано у 14 м 3 зону забруднення ґрунтових вод трихлороетиленом. • Ефективність відновлення трихлороетилену досягала 96% упродовж 4 -тижневого моніторингу.
 Залізо нульової валентності
Залізо нульової валентності
 Nanosized ZVI
Nanosized ZVI
 Деградація пестицидів залізом нульової віалентності
Деградація пестицидів залізом нульової віалентності
 БІМЕТАЛЕВІ НАНОЧАСТИНКИ • Залізо окиснюється значно швидче, коли • Наприклад, біметалеві воно приєднується до наночастинки на основі менш активного заліза (99. 9 %) з (благородного) металу паладієм (0. 1 %) (наприклад, Pd, Ag, Cu, викликають деградацію Co, Ni). забруднювачів на два порядки швидшу в • Отже, перетворення порівнянні з забруднювачів результатами навколишнього застосування лише середовища залізних частинок покращується внаслідок (Zhang and Elliot 2006). застосування біметалевих наночастинок (Pd/Fe, Pd/Zn, Pt/Fe, Ni/Fe).
БІМЕТАЛЕВІ НАНОЧАСТИНКИ • Залізо окиснюється значно швидче, коли • Наприклад, біметалеві воно приєднується до наночастинки на основі менш активного заліза (99. 9 %) з (благородного) металу паладієм (0. 1 %) (наприклад, Pd, Ag, Cu, викликають деградацію Co, Ni). забруднювачів на два порядки швидшу в • Отже, перетворення порівнянні з забруднювачів результатами навколишнього застосування лише середовища залізних частинок покращується внаслідок (Zhang and Elliot 2006). застосування біметалевих наночастинок (Pd/Fe, Pd/Zn, Pt/Fe, Ni/Fe).
 БІМЕТАЛЕВІ НАНОЧАСТИНКИ Благородні метали у даному випадку виконують функції каталізатора – речовини, яка змінює швидкість хімічних реакцій, а сама після реакції залишається хімічно незмінною і в тій же кількості, що й до реакції.
БІМЕТАЛЕВІ НАНОЧАСТИНКИ Благородні метали у даному випадку виконують функції каталізатора – речовини, яка змінює швидкість хімічних реакцій, а сама після реакції залишається хімічно незмінною і в тій же кількості, що й до реакції.
 Zero-Valent Iron and Bimetallic Nanoparticles (Elliot and Zhang, 2001; Li et al. , 2006)
Zero-Valent Iron and Bimetallic Nanoparticles (Elliot and Zhang, 2001; Li et al. , 2006)
 ЕМУЛЬСИФІКОВАНІ ЧАСТИНКИ • Серйозну проблему становить наявність у ґрунтових водах рідин неводної фази (Non. Aqueous Phase Liquids або NAPL), густина яких перевищує густину води та які не змішуються та не розчиняються у воді.
ЕМУЛЬСИФІКОВАНІ ЧАСТИНКИ • Серйозну проблему становить наявність у ґрунтових водах рідин неводної фази (Non. Aqueous Phase Liquids або NAPL), густина яких перевищує густину води та які не змішуються та не розчиняються у воді.
 ЕМУЛЬСИФІКОВАНІ ЧАСТИНКИ Емульсифіковані частинки заліза нульової валентності (ЕЗНВ) являють собою наночастинки заліза, які покриті емульсійною мембраною, що полегшує обробку хлорованих вуглеводнів.
ЕМУЛЬСИФІКОВАНІ ЧАСТИНКИ Емульсифіковані частинки заліза нульової валентності (ЕЗНВ) являють собою наночастинки заліза, які покриті емульсійною мембраною, що полегшує обробку хлорованих вуглеводнів.
 ЕМУЛЬСИФІКОВАНІ ЧАСТИНКИ • Емульсійна мембрана виготовлена з сурфактанту та олії, що розкладається мікроорганізмами, тоді як внутрішній простір краплини містить воду та частинки заліза нульової валентності. • Оскільки зовнішня сторона мембрани має гідрофобні властивості, такі як у рідин неводної фази, емульсія здатна змішуватися з цими рідинами.
ЕМУЛЬСИФІКОВАНІ ЧАСТИНКИ • Емульсійна мембрана виготовлена з сурфактанту та олії, що розкладається мікроорганізмами, тоді як внутрішній простір краплини містить воду та частинки заліза нульової валентності. • Оскільки зовнішня сторона мембрани має гідрофобні властивості, такі як у рідин неводної фази, емульсія здатна змішуватися з цими рідинами.
 ЕМУЛЬСИФІКОВАНІ ЧАСТИНКИ • Отже, забруднююча речовина дифундує у середину краплини, де входить у контакт з ЗНВ та деградує. Деградації також сприяє олія та сурфактанти, які є донорами електронів.
ЕМУЛЬСИФІКОВАНІ ЧАСТИНКИ • Отже, забруднююча речовина дифундує у середину краплини, де входить у контакт з ЗНВ та деградує. Деградації також сприяє олія та сурфактанти, які є донорами електронів.
 ЕМУЛЬСИФІКОВАНІ ЧАСТИНКИ Емульсифіковані частинки заліза нульової валентності були застосовані для очищення ґрунту та ґрунтових вод від трихлороетилену на авіаційній базі США (Patrick Air Force Base) у Флориді. Якщо початкова концентрація трихлороетилену була 150000 мкг/л, та внаслідок обробки вона зменшилася до рівня 3580 мкг/л.
ЕМУЛЬСИФІКОВАНІ ЧАСТИНКИ Емульсифіковані частинки заліза нульової валентності були застосовані для очищення ґрунту та ґрунтових вод від трихлороетилену на авіаційній базі США (Patrick Air Force Base) у Флориді. Якщо початкова концентрація трихлороетилену була 150000 мкг/л, та внаслідок обробки вона зменшилася до рівня 3580 мкг/л.
 Наночастинки - Висновки • Процес відновлення забруднювачів супроводжується їх перетворенням у менш токсичну і навіть у безпечну форми. • Застосування наночастинок дає можливість очистити ґрунт, ґрунтові води та седименти від важких металів (ртуть, свинець, кадмій) та органічних сполук (бензол, хлоровані розчинники, креозот, толуол)
Наночастинки - Висновки • Процес відновлення забруднювачів супроводжується їх перетворенням у менш токсичну і навіть у безпечну форми. • Застосування наночастинок дає можливість очистити ґрунт, ґрунтові води та седименти від важких металів (ртуть, свинець, кадмій) та органічних сполук (бензол, хлоровані розчинники, креозот, толуол)
 НАНОМАТЕРІАЛИ • Наноматеріли – це матеріали з морфологічними рисами нанооб’єктів та які мають специфічні властивості, що випливають з їх нанорозмірів.
НАНОМАТЕРІАЛИ • Наноматеріли – це матеріали з морфологічними рисами нанооб’єктів та які мають специфічні властивості, що випливають з їх нанорозмірів.
 Наноматеріали • Упродовж останніх років було розроблено та виготовлено велику кількість наноматеріалів, придатних для ремедіації навколишнього середовища. Вони застосовуються для очищення ґрунту та ґрунтових вод від хлорованих розчинників та залишків нафтопродуктів. • Ця підвищена реактивність пояснюється наявністю великої кількості реактивних ділянок, що дозволяє покращити контакт з забруднюючими речовинами та забезпечити швидке зменшення їх концентрації. • Крім того, завдяки малим розмірам наноматеріали можуть бути легко суспендовані у ґрунтових водах, що забезпечує їх більш широке поширення.
Наноматеріали • Упродовж останніх років було розроблено та виготовлено велику кількість наноматеріалів, придатних для ремедіації навколишнього середовища. Вони застосовуються для очищення ґрунту та ґрунтових вод від хлорованих розчинників та залишків нафтопродуктів. • Ця підвищена реактивність пояснюється наявністю великої кількості реактивних ділянок, що дозволяє покращити контакт з забруднюючими речовинами та забезпечити швидке зменшення їх концентрації. • Крім того, завдяки малим розмірам наноматеріали можуть бути легко суспендовані у ґрунтових водах, що забезпечує їх більш широке поширення.
 Графен та фулерен Графе н – двовимірна модифікація вуглецю, що утворена шаром атомів вуглецю товщиною в один атом та з’єднаних у гексагональну решітку. Фулерен – будь-яка молекула, що складається з вуглецю та має форму порожнистої сфери або трубки.
Графен та фулерен Графе н – двовимірна модифікація вуглецю, що утворена шаром атомів вуглецю товщиною в один атом та з’єднаних у гексагональну решітку. Фулерен – будь-яка молекула, що складається з вуглецю та має форму порожнистої сфери або трубки.
 Лауреати Нобелівської премії 2010 р. • The Royal Swedish Academy of Sciences has awarded the Nobel Prize in Physics for 2010 to Andre Geim and Konstantin Novoselov, both of the University of Manchester, "for groundbreaking experiments regarding the two-dimensional material graphene. "
Лауреати Нобелівської премії 2010 р. • The Royal Swedish Academy of Sciences has awarded the Nobel Prize in Physics for 2010 to Andre Geim and Konstantin Novoselov, both of the University of Manchester, "for groundbreaking experiments regarding the two-dimensional material graphene. "

 САМООРГАНІЗУЮЧІ МОНОШАРИ НА МЕЗОПОРИСТІЙ ПІДКЛАДЦІ • Деякі матеріали вироблені з • Хоча самі SAMMSTM поверхневими матеріали розмірами функціональними перевищують групами, що виконують нанодіапазон, вони функції сорбентів для вважаються вилучення специфічних наноматеріалами, забруднювачів з рідких оскільки містять середовищ, стічних вод, нанопори (розмірами 2 промислових відходів. -20 нм). Ці матеріали мають велику поверхню • Серед них - (~1000 м 2/г), завдяки самоорганізуючі якій здійснюється моношари на швидка сорбційна мезопористій підкладці кінетика. (self-assembled monolayers on mesoporous supports- SAMMSTM).
САМООРГАНІЗУЮЧІ МОНОШАРИ НА МЕЗОПОРИСТІЙ ПІДКЛАДЦІ • Деякі матеріали вироблені з • Хоча самі SAMMSTM поверхневими матеріали розмірами функціональними перевищують групами, що виконують нанодіапазон, вони функції сорбентів для вважаються вилучення специфічних наноматеріалами, забруднювачів з рідких оскільки містять середовищ, стічних вод, нанопори (розмірами 2 промислових відходів. -20 нм). Ці матеріали мають велику поверхню • Серед них - (~1000 м 2/г), завдяки самоорганізуючі якій здійснюється моношари на швидка сорбційна мезопористій підкладці кінетика. (self-assembled monolayers on mesoporous supports- SAMMSTM).
 САМООРГАНІЗУЮЧІ МОНОШАРИ НА МЕЗОПОРИСТІЙ ПІДКЛАДЦІ Ці наноматеріали містять нанопористий керамічний субстрат, покритий моношаром функціональних груп, які одним кінцем прив’язуються до кремнієвого субстрату, а другим – до забруднюючої речовини.
САМООРГАНІЗУЮЧІ МОНОШАРИ НА МЕЗОПОРИСТІЙ ПІДКЛАДЦІ Ці наноматеріали містять нанопористий керамічний субстрат, покритий моношаром функціональних груп, які одним кінцем прив’язуються до кремнієвого субстрату, а другим – до забруднюючої речовини.
 САМООРГАНІЗУЮЧІ МОНОШАРИ НА МЕЗОПОРИСТІЙ ПІДКЛАДЦІ • Засостовують SAMMSTM матеріали для сорбції таких забруднювачів як радіонукліди, ртуть, хромати, арсенити, селенити (Mattigod 2003; Tratnyek and • Johnson пудри SAMMS™ 5 грамів 2006). забезпечує площу поверхні, еквівалентну футбольному полю. Зв’язуючі молекули повністю покривають цю поверхню.
САМООРГАНІЗУЮЧІ МОНОШАРИ НА МЕЗОПОРИСТІЙ ПІДКЛАДЦІ • Засостовують SAMMSTM матеріали для сорбції таких забруднювачів як радіонукліди, ртуть, хромати, арсенити, селенити (Mattigod 2003; Tratnyek and • Johnson пудри SAMMS™ 5 грамів 2006). забезпечує площу поверхні, еквівалентну футбольному полю. Зв’язуючі молекули повністю покривають цю поверхню.
 НАНОТРУБКИ • Нанотрубки, виготовлені з діоксиду титана, здатні виконувати функції фотокаталізаторів, тобто прискорювати хімічні реакції під впливом світла (сонячного випромінювання). • Ці нанотрубки мають надзвичайно велику поверхню, що забезпечує їх ефективність.
НАНОТРУБКИ • Нанотрубки, виготовлені з діоксиду титана, здатні виконувати функції фотокаталізаторів, тобто прискорювати хімічні реакції під впливом світла (сонячного випромінювання). • Ці нанотрубки мають надзвичайно велику поверхню, що забезпечує їх ефективність.
 НАНОТРУБКИ Під впливом сонячного світла, кисню з повітря та води ТіО 2 утворює вільні радикали, які здатні зруйнувати органічні та неорганічні забруднювачі атмосфери, серед яких є SO 2, NOx, CO, бензол, поліциклічні ароматичні вуглеводні. Також розкладаються на безпечні молекули води та двоокису вуглецю леткі хімічні сполуки, віруси, бактерії.
НАНОТРУБКИ Під впливом сонячного світла, кисню з повітря та води ТіО 2 утворює вільні радикали, які здатні зруйнувати органічні та неорганічні забруднювачі атмосфери, серед яких є SO 2, NOx, CO, бензол, поліциклічні ароматичні вуглеводні. Також розкладаються на безпечні молекули води та двоокису вуглецю леткі хімічні сполуки, віруси, бактерії.
 Очищення повітря • У 19 районі Парижу на території, де знаходяться канали та покинуті залізничні колії, знаходиться будівля, яка є каталізатором чистого повітря.
Очищення повітря • У 19 районі Парижу на території, де знаходяться канали та покинуті залізничні колії, знаходиться будівля, яка є каталізатором чистого повітря.
 Очищення повітря • Зовнішня поверхня нової архітектурної будівлі складається з більш ніж 250 квадратних метрів сонячних фотоелектричних панелей та покрита діоксидом титану. • За рахунок природного ультрафіолетового випромінювання ТіО 2 взаємодіє з твердими частинками повітря та вилучає забруднювачі з повітря.
Очищення повітря • Зовнішня поверхня нової архітектурної будівлі складається з більш ніж 250 квадратних метрів сонячних фотоелектричних панелей та покрита діоксидом титану. • За рахунок природного ультрафіолетового випромінювання ТіО 2 взаємодіє з твердими частинками повітря та вилучає забруднювачі з повітря.
 ФЕРИТИНИ • Феритин – це глобулярний білковий комплекс, що накопичує внутрішньоклітинне залізо. • Міститься майже у всіх живих організмах – бактеріях, водоростях, рослинах, тваринах. • Накопичене залізо добре розчиняється та нетоксичне.
ФЕРИТИНИ • Феритин – це глобулярний білковий комплекс, що накопичує внутрішньоклітинне залізо. • Міститься майже у всіх живих організмах – бактеріях, водоростях, рослинах, тваринах. • Накопичене залізо добре розчиняється та нетоксичне.
 ФЕРИТИНИ • • Феритини застосовуються під час виробництва наночастинок. Міжмолекулярні простори білків виконують функції шаблонів або трафаретів для наночастинок: використовуючи білки різних розмірів, можна синтезувати наночастинки різних калібрів. • Змінюючи кількість заліза у білках, можна варіювати розміри частинок.
ФЕРИТИНИ • • Феритини застосовуються під час виробництва наночастинок. Міжмолекулярні простори білків виконують функції шаблонів або трафаретів для наночастинок: використовуючи білки різних розмірів, можна синтезувати наночастинки різних калібрів. • Змінюючи кількість заліза у білках, можна варіювати розміри частинок.
 ФЕРИТИНИ • Феритин застосовують для зменшення токсичності таких забруднювачів як хром та технецій в поверхневих та ґрунтових водах. Зокрема, відбулося перетворення під впливом оптичного випромінювання Хрому-6 у Хром-3, який не розчиняється у воді. • Технецій-7 є об’єктом радіоактивних відходів під Вашингтоном: великі каністри з цими відходами були заховані в 40 -х та 50 -х роках і зараз вони повільно протікають. • Застосування наночастинок дає надію на можливе очищення ґрунтових вод.
ФЕРИТИНИ • Феритин застосовують для зменшення токсичності таких забруднювачів як хром та технецій в поверхневих та ґрунтових водах. Зокрема, відбулося перетворення під впливом оптичного випромінювання Хрому-6 у Хром-3, який не розчиняється у воді. • Технецій-7 є об’єктом радіоактивних відходів під Вашингтоном: великі каністри з цими відходами були заховані в 40 -х та 50 -х роках і зараз вони повільно протікають. • Застосування наночастинок дає надію на можливе очищення ґрунтових вод.
 ДЕНДРИМЕРИ • Дендримери – надзвичайно розгалужені полімери, які можуть являти собою різноманітні функціональні групи конусоподібної, сферичної та дископодібної форми. Cлово “дендример” походить від грецького ”dendron” - дерево. Зазвичай, дендример має двовимірну або тривимірну симетричну відносно центру форму.
ДЕНДРИМЕРИ • Дендримери – надзвичайно розгалужені полімери, які можуть являти собою різноманітні функціональні групи конусоподібної, сферичної та дископодібної форми. Cлово “дендример” походить від грецького ”dendron” - дерево. Зазвичай, дендример має двовимірну або тривимірну симетричну відносно центру форму.
 ДЕНДРИМЕРИ • Дендримери відносяться до класу полімерних сполук, молекули яких мають велику кількість розгалужень. • Завдяки зітканню «гілок» розгалужень утворюються внутрішні порожнини, в яких можуть знаходитися невеликі молекули, що хімічно з’єднані з дендримером. • Регулюючи розміри міцел та відстані між ними під час синтезу, можна створювати молекулярні сита із заданими порами.
ДЕНДРИМЕРИ • Дендримери відносяться до класу полімерних сполук, молекули яких мають велику кількість розгалужень. • Завдяки зітканню «гілок» розгалужень утворюються внутрішні порожнини, в яких можуть знаходитися невеликі молекули, що хімічно з’єднані з дендримером. • Регулюючи розміри міцел та відстані між ними під час синтезу, можна створювати молекулярні сита із заданими порами.
 ДЕНДРИМЕРИ Так, синтез Fe 0/Fe. S частинок з використанням дендримера як шаблону надає можливість створювати проникні реактивні бар’єри для ремедіації забруднених ґрунтових вод (Diallo et al. 2006; Xu 2006).
ДЕНДРИМЕРИ Так, синтез Fe 0/Fe. S частинок з використанням дендримера як шаблону надає можливість створювати проникні реактивні бар’єри для ремедіації забруднених ґрунтових вод (Diallo et al. 2006; Xu 2006).
 МЕТАЛОПОРФІРИНИ • Металопорфірини являють собою комплекси металів з природними молекулами порфірину, в якій металевий іон зв’язаний з чотирма атомами азоту у пірольному кільці. • Прикладами металопорфіринів є гемоглобін та вітамин В 12. Структура порфіну – найпростішого порфірину Гемова група гемоглобіну
МЕТАЛОПОРФІРИНИ • Металопорфірини являють собою комплекси металів з природними молекулами порфірину, в якій металевий іон зв’язаний з чотирма атомами азоту у пірольному кільці. • Прикладами металопорфіринів є гемоглобін та вітамин В 12. Структура порфіну – найпростішого порфірину Гемова група гемоглобіну
 МЕТАЛОПОРФІРИНИ Експерименти (Dror et al. 2005) продемонстрували, що металопорфірини здатні відновлювати хлоровані вуглеводні такі як тетрахлорид вуглецю, тетрахлороетилен та трихлороетилен у забрудненому ґрунті та ґрунтових водах.
МЕТАЛОПОРФІРИНИ Експерименти (Dror et al. 2005) продемонстрували, що металопорфірини здатні відновлювати хлоровані вуглеводні такі як тетрахлорид вуглецю, тетрахлороетилен та трихлороетилен у забрудненому ґрунті та ґрунтових водах.
 МЕТАЛОПОРФІРИНИ Найважливішою особливістю порфіринів є наявність у молекулі координаційної порожнини, обмеженої атомами азоту та здатної координувати іони металів М 2+, М 3+, М 4+ і навіть з більшим ступенем окиснення.
МЕТАЛОПОРФІРИНИ Найважливішою особливістю порфіринів є наявність у молекулі координаційної порожнини, обмеженої атомами азоту та здатної координувати іони металів М 2+, М 3+, М 4+ і навіть з більшим ступенем окиснення.
 SOMS (Swells of Organically Modified Silica) або Osorb (Organic Sorbtion) SOMS (комерційна назва Osorb) є органічно модифікований кремнезем, який здувається та захоплює такі дрібні молекули органічних сполук як бензин, природний газ, ацетон, етанол тощо.
SOMS (Swells of Organically Modified Silica) або Osorb (Organic Sorbtion) SOMS (комерційна назва Osorb) є органічно модифікований кремнезем, який здувається та захоплює такі дрібні молекули органічних сполук як бензин, природний газ, ацетон, етанол тощо.
 SOMS-Osorb SOMS здатний збільшувати свій об’єм у 8 разів внаслідок захоплення органічних сполук.
SOMS-Osorb SOMS здатний збільшувати свій об’єм у 8 разів внаслідок захоплення органічних сполук.
 SOMS-Osorb • SOMS-прилад був апробований у Мексиканській затоці (Boccieri 2010). ABS Materials. 2010 B. Osorb Web page. Available at: http: //www. absmaterials. com/osorb. Accessed July 31, 2010.
SOMS-Osorb • SOMS-прилад був апробований у Мексиканській затоці (Boccieri 2010). ABS Materials. 2010 B. Osorb Web page. Available at: http: //www. absmaterials. com/osorb. Accessed July 31, 2010.
 Нанофільтрація • Нанофільтрація затримує вибірково органічні молекули, пестициди, природні та штучні гормони, мультивалентні іони та абсолютно всі типи бактерій і вірусів. Переріз нанопористої плівки (Image: Dr. Kim, POSTECH)
Нанофільтрація • Нанофільтрація затримує вибірково органічні молекули, пестициди, природні та штучні гормони, мультивалентні іони та абсолютно всі типи бактерій і вірусів. Переріз нанопористої плівки (Image: Dr. Kim, POSTECH)
 Нанофільтрація • Нанофільтрація не вилучає всі речовини із води. Відфільтровуються великі за розміром шкідливі домішки (наприклад, пестициди і важкі метали), а у воді залишаються безпечні сполуки (наприклад, хлориди, іони натрію тощо).
Нанофільтрація • Нанофільтрація не вилучає всі речовини із води. Відфільтровуються великі за розміром шкідливі домішки (наприклад, пестициди і важкі метали), а у воді залишаються безпечні сполуки (наприклад, хлориди, іони натрію тощо).
 Опріснення морських та підземних солених вод • ПИТНА ВОДА І МЕМБРАННІ ТЕХНОЛОГІЇ: • ДОСЯГНЕННЯ ТА ПЕРСПЕКТИВИ • М. Т. Брик, А. Ф. Бурбан, В. В. Коновалова, А. Л. Алпатова • Національний університет "Києво. Могилянська академія", м. Київ “Найбільш ефективною безреагентною мембранною технологією підготовки питної води є нанофільтрація, використання якої швидко розширюється в США і країнах Західної Європи”.
Опріснення морських та підземних солених вод • ПИТНА ВОДА І МЕМБРАННІ ТЕХНОЛОГІЇ: • ДОСЯГНЕННЯ ТА ПЕРСПЕКТИВИ • М. Т. Брик, А. Ф. Бурбан, В. В. Коновалова, А. Л. Алпатова • Національний університет "Києво. Могилянська академія", м. Київ “Найбільш ефективною безреагентною мембранною технологією підготовки питної води є нанофільтрація, використання якої швидко розширюється в США і країнах Західної Європи”.
 Осмос • Осмос – це проникнення чистого розчинника через напівпроникну мембрану в розчин. Для водних розчинів осмос означає перехід води із ділянки з високою концентрацією води у ділянку з низькою концентрацією води.
Осмос • Осмос – це проникнення чистого розчинника через напівпроникну мембрану в розчин. Для водних розчинів осмос означає перехід води із ділянки з високою концентрацією води у ділянку з низькою концентрацією води.
 Зворотний осмос • Якщо з боку розчину з більшою концентрацією солей створити певний гідростатичний тиск, то відбувається зворотний процес – зворотний осмос: молекули води починають проникати через пори мембрани з розчину більшої концентрації солей у розчин з меншою концентрацією, причому всі розчинені у воді солі (домішки) не проходять через мембрану та концентруються.
Зворотний осмос • Якщо з боку розчину з більшою концентрацією солей створити певний гідростатичний тиск, то відбувається зворотний процес – зворотний осмос: молекули води починають проникати через пори мембрани з розчину більшої концентрації солей у розчин з меншою концентрацією, причому всі розчинені у воді солі (домішки) не проходять через мембрану та концентруються.
 Зворотний осмос
Зворотний осмос
 Тиск під час зворотного осмосу • Величина осмотичного тиску прямо пропорційна до концентрації розчинених речовин та абсолютної температури (температури за шкалою Кельвіна). • Так, наприклад, для морської води із вмістом солей 35 г/л осмотичний тиск становить близько 25 ат. • Для прісної води, що містить солей 0, 5 – 1, 0 г/л, осмотичний тиск дорівнює 2 -3 ат.
Тиск під час зворотного осмосу • Величина осмотичного тиску прямо пропорційна до концентрації розчинених речовин та абсолютної температури (температури за шкалою Кельвіна). • Так, наприклад, для морської води із вмістом солей 35 г/л осмотичний тиск становить близько 25 ат. • Для прісної води, що містить солей 0, 5 – 1, 0 г/л, осмотичний тиск дорівнює 2 -3 ат.
 Проблеми зворотного осмосу Як свідчать дослідження, проведені у Південній Африці, випробування зворотного наноосмосу по опрісненню солоної води призвели до вилучення навіть не лише солей, але й поживних субстанцій (кальцію, магнію тощо), після чого вода не відповідала вимогам Всесвітньої Організації Здоров’я (World Health Organization).
Проблеми зворотного осмосу Як свідчать дослідження, проведені у Південній Африці, випробування зворотного наноосмосу по опрісненню солоної води призвели до вилучення навіть не лише солей, але й поживних субстанцій (кальцію, магнію тощо), після чого вода не відповідала вимогам Всесвітньої Організації Здоров’я (World Health Organization).

 Застосування нанофільтрації • Нанофільтрація затримує вибірково органічні молекули, великі іони та абсолютно всі типи бактерій і вірусів. • Крім того, нанофільтрація забезпечує зм’якшення води: після очищення жорсткість води зменшується приблизно у 10 -15 разів.
Застосування нанофільтрації • Нанофільтрація затримує вибірково органічні молекули, великі іони та абсолютно всі типи бактерій і вірусів. • Крім того, нанофільтрація забезпечує зм’якшення води: після очищення жорсткість води зменшується приблизно у 10 -15 разів.
 МІКРОБІОЛОГІЧНИЙ СИНТЕЗ НАНОЧАСТИНОК • Якщо розмістити бактерію Pseudomonas stutzeri у концентрований розчин Ag. NO 3, відбувається відновлення іонів Ag+ та утворення срібних наночастинок у внутрішньому просторі бактерії. • Актиноміцети Rhodococcus sp. Здатні синтезувати золоті наночастинки. • Ацидофільні гриби Verticilium sp. призводять до накопичення срібних та золотих наночастинок
МІКРОБІОЛОГІЧНИЙ СИНТЕЗ НАНОЧАСТИНОК • Якщо розмістити бактерію Pseudomonas stutzeri у концентрований розчин Ag. NO 3, відбувається відновлення іонів Ag+ та утворення срібних наночастинок у внутрішньому просторі бактерії. • Актиноміцети Rhodococcus sp. Здатні синтезувати золоті наночастинки. • Ацидофільні гриби Verticilium sp. призводять до накопичення срібних та золотих наночастинок
 Наночастинки срібла • Наночастинки срібла акумулюються клітинами бактерії Pseudomonas stuzeri AG 259 (35 -46 нм) (Haefeli et al. , 1984; Klaus et al. , 1999) та Bacillus sp. (5 -15 нм) (Pugazhenthiran et al. , 2009).
Наночастинки срібла • Наночастинки срібла акумулюються клітинами бактерії Pseudomonas stuzeri AG 259 (35 -46 нм) (Haefeli et al. , 1984; Klaus et al. , 1999) та Bacillus sp. (5 -15 нм) (Pugazhenthiran et al. , 2009).
 Наночастинки золота • Bacillus subtilis 168 характеризується здатністю відновлювати іони Au 3+ та утворювати частинки золота (5 -25 нм) внаслідок інкубації клітин у розчин хлориду золота (Southam and Beveridge, 1994). • Наночастинки золота (10 -20 нм) були синтезовані у бактерії Shewanella algae (Klaus et al. , 1999).
Наночастинки золота • Bacillus subtilis 168 характеризується здатністю відновлювати іони Au 3+ та утворювати частинки золота (5 -25 нм) внаслідок інкубації клітин у розчин хлориду золота (Southam and Beveridge, 1994). • Наночастинки золота (10 -20 нм) були синтезовані у бактерії Shewanella algae (Klaus et al. , 1999).

 Магнітні наночастинки • Магнітні наночастинки здатні зв’язуватися з забруднювачами – арсеном та нафтопродуктами та вилучатися • Магнітні частинки забезпечують ефективне вилучення важких металів зі стічних вод за допомогою магнітної сепарації. • Наприклад, дослідницька команда з Rice University in the United States застосувала магнітну “наноіржу”для вилучення арсену з питної води. • Велика поверхня наноіржиі дозволяє захопити у кілька сотень разів більше арсену, ніж при застосуванні великих частинок. • Вважається, що 200– 500 міліграмів наноіржі забезпечить очищення літра води.
Магнітні наночастинки • Магнітні наночастинки здатні зв’язуватися з забруднювачами – арсеном та нафтопродуктами та вилучатися • Магнітні частинки забезпечують ефективне вилучення важких металів зі стічних вод за допомогою магнітної сепарації. • Наприклад, дослідницька команда з Rice University in the United States застосувала магнітну “наноіржу”для вилучення арсену з питної води. • Велика поверхня наноіржиі дозволяє захопити у кілька сотень разів більше арсену, ніж при застосуванні великих частинок. • Вважається, що 200– 500 міліграмів наноіржі забезпечить очищення літра води.
 Магнетотактичні бактерії • Магнетотактичні бактерії мають фіксований ланцюг з близько 20 магнітних кристалів розмірами 35100 нм. • Ці бактерії здатні іммобілізувати важкі метали з оточуючого розчину. • Прикладання низькоінтенсивного сфокусованого магнітного поля дає можливість виділити ці метали.
Магнетотактичні бактерії • Магнетотактичні бактерії мають фіксований ланцюг з близько 20 магнітних кристалів розмірами 35100 нм. • Ці бактерії здатні іммобілізувати важкі метали з оточуючого розчину. • Прикладання низькоінтенсивного сфокусованого магнітного поля дає можливість виділити ці метали.
 Магнетотактичні бактерії • One reported example includes large (up to 200 nm) magnetosomes found in coccoid cells in Brazil. These cells have enough magnetosomes so that the calculated magnetic dipole moment of the cell is about 250 times larger than that of a typical cell of Magnetospirillum magnetotacticum. • There also examples of magnetotactic bacteria that contain hundreds of magnetosomes, many more than required for orientation. • One large, rod-shaped organism, Magnetobacterium bavaricum, contains up to 1000 bulletshaped magnetosomes arranged in several chains traversing the cell.
Магнетотактичні бактерії • One reported example includes large (up to 200 nm) magnetosomes found in coccoid cells in Brazil. These cells have enough magnetosomes so that the calculated magnetic dipole moment of the cell is about 250 times larger than that of a typical cell of Magnetospirillum magnetotacticum. • There also examples of magnetotactic bacteria that contain hundreds of magnetosomes, many more than required for orientation. • One large, rod-shaped organism, Magnetobacterium bavaricum, contains up to 1000 bulletshaped magnetosomes arranged in several chains traversing the cell.
 Магнетотактичні бактерії • Застосовуються магнетотактичні бактерії для очищення стічних вод від небезпечних металів – продуктів виробництва важких металів та ядерної промисловості. Magnetospirillum magnetotacticum http: //telem. openu. ac. il/courses/c 20 237/magneto. htm
Магнетотактичні бактерії • Застосовуються магнетотактичні бактерії для очищення стічних вод від небезпечних металів – продуктів виробництва важких металів та ядерної промисловості. Magnetospirillum magnetotacticum http: //telem. openu. ac. il/courses/c 20 237/magneto. htm
 МАГНЕТОСОМИ • Ланцюжки магнетосом — мембранні органели, знайдені у деяких магнетотактичних бактерій. Вони містять від 15 до 20 кристалів магнетиту довжиною 40 -60 нм, які разом діють подібно до голки компаса, орієнтуючи магнетотактичних бактерій у магнітному полі Землі Магнетотактична бактерія з ланцюгом кристалів магнетиту
МАГНЕТОСОМИ • Ланцюжки магнетосом — мембранні органели, знайдені у деяких магнетотактичних бактерій. Вони містять від 15 до 20 кристалів магнетиту довжиною 40 -60 нм, які разом діють подібно до голки компаса, орієнтуючи магнетотактичних бактерій у магнітному полі Землі Магнетотактична бактерія з ланцюгом кристалів магнетиту
 МАГНЕТОСОМИ Магнетотактична бактерія з ланцюгом кристалів магнетиту
МАГНЕТОСОМИ Магнетотактична бактерія з ланцюгом кристалів магнетиту
 Функції магнетиту • • Здатність живих організмів сприймати та використовувати зовнішні магнітні поля називається магніторецепцією. На сучасному рівні найвірогіднішою є гіпотеза магніторецепції, яка основана на концепції магнетиту специфічної неорганічної сполуки заліза. Магнетит знайдений у голубів, пелагічних китів, деяких молюсків та бактерій, що мешкають в мулі. Уміщений у магнітне поле, цей магнетит проявляє себе як стрілка компасу, орієнтуючись вздовж поля. Поведінка магнетотактичної бактерії відносно магнітного поля Землі
Функції магнетиту • • Здатність живих організмів сприймати та використовувати зовнішні магнітні поля називається магніторецепцією. На сучасному рівні найвірогіднішою є гіпотеза магніторецепції, яка основана на концепції магнетиту специфічної неорганічної сполуки заліза. Магнетит знайдений у голубів, пелагічних китів, деяких молюсків та бактерій, що мешкають в мулі. Уміщений у магнітне поле, цей магнетит проявляє себе як стрілка компасу, орієнтуючись вздовж поля. Поведінка магнетотактичної бактерії відносно магнітного поля Землі
 Heavy Metals • The term heavy metal refers to any metallic chemical element that has a relatively high density and is toxic or poisonous at low concentrations. Examples of heavy metals include mercury (Hg), cadmium (Cd), arsenic (As), chromium (Cr), thallium (ТІ), and lead (Pb).
Heavy Metals • The term heavy metal refers to any metallic chemical element that has a relatively high density and is toxic or poisonous at low concentrations. Examples of heavy metals include mercury (Hg), cadmium (Cd), arsenic (As), chromium (Cr), thallium (ТІ), and lead (Pb).
 Вилучення важких металів • Традиційні методи вилучення важких металів достатньо дорогі та неефективні, особливо коли йдеться про низькі концентрації у розчинах. • Застосування наноматеріалів є альтернативою традиційним методам завдяки великій площі поверхні, високому рівню адгезії та новим властивостям наноматералів.
Вилучення важких металів • Традиційні методи вилучення важких металів достатньо дорогі та неефективні, особливо коли йдеться про низькі концентрації у розчинах. • Застосування наноматеріалів є альтернативою традиційним методам завдяки великій площі поверхні, високому рівню адгезії та новим властивостям наноматералів.
 ВИЛУЧЕННЯ ВАЖКИХ МЕТАЛІВ • На відміну від інших • Застосування забруднювачів, мікроорганізмів до метали важко вилучення або вилучити з довкілля, нейтралізації важких оскільки вони не металів пригорнуло підлягають хімічній особливу увагу та біологічній упродовж останнього деградації та часу через низьку неруйнівні. собівартість та високу ефективність.
ВИЛУЧЕННЯ ВАЖКИХ МЕТАЛІВ • На відміну від інших • Застосування забруднювачів, мікроорганізмів до метали важко вилучення або вилучити з довкілля, нейтралізації важких оскільки вони не металів пригорнуло підлягають хімічній особливу увагу та біологічній упродовж останнього деградації та часу через низьку неруйнівні. собівартість та високу ефективність.
 Нанозабруднення • Нанозабруднення викликаються наночастинками внаслідок виробництва приладів на їх основі. • Малі розміри наночастинок зумовлюють небезпеку для рослин, тварин та здоров’я людини. • Оскільки у природному стані наночастинки відсутні, живі організми не мають засобів захисту від них. Група опозиціонерів нанотехнологіям розмістила гасло поблизу нанотехнологічної лабораторії у Греноблі, Франція.
Нанозабруднення • Нанозабруднення викликаються наночастинками внаслідок виробництва приладів на їх основі. • Малі розміри наночастинок зумовлюють небезпеку для рослин, тварин та здоров’я людини. • Оскільки у природному стані наночастинки відсутні, живі організми не мають засобів захисту від них. Група опозиціонерів нанотехнологіям розмістила гасло поблизу нанотехнологічної лабораторії у Греноблі, Франція.
 Нанозабруднення • Серед небезпечних наночастинок слід зазначити ті, що накопичуються у харчових ланцюгах: • Aзбест; • Частинки дизельного палива; • Ультрадрібні частинки; • ДДТ; • Свинець. Варто додати, що небезпека цих частинок відома вже багато років.
Нанозабруднення • Серед небезпечних наночастинок слід зазначити ті, що накопичуються у харчових ланцюгах: • Aзбест; • Частинки дизельного палива; • Ультрадрібні частинки; • ДДТ; • Свинець. Варто додати, що небезпека цих частинок відома вже багато років.
 Наноматеріали Електронний блок з золотим покриттям
Наноматеріали Електронний блок з золотим покриттям
 ВПЛИВ НАНОМАТЕРІАЛІВ НА ЗДОРОВ’Я ЛЮДИНИ ТА ДОВКІЛЛЯ U. S. Environmental Protection Agency Nanotechnology White Paper EPA 100/B-07/001 | February 2007 www. epa. gov/osa
ВПЛИВ НАНОМАТЕРІАЛІВ НА ЗДОРОВ’Я ЛЮДИНИ ТА ДОВКІЛЛЯ U. S. Environmental Protection Agency Nanotechnology White Paper EPA 100/B-07/001 | February 2007 www. epa. gov/osa
 Літературні джерела • Є суттєва прогалина у наших знаннях щодо впливу нанотехнологій на здоров’я людини та навколишнє середовище (Dreher, 2004; Swiss Report, 2004; UK Royal Society, 2004; European Nano. Safe, 2004; UK Health and Safety Executive, 2004). • На рисунку наведено результати аналізу літературних джерел, до 2005 р. присвячених частинкам та їх токсичності
Літературні джерела • Є суттєва прогалина у наших знаннях щодо впливу нанотехнологій на здоров’я людини та навколишнє середовище (Dreher, 2004; Swiss Report, 2004; UK Royal Society, 2004; European Nano. Safe, 2004; UK Health and Safety Executive, 2004). • На рисунку наведено результати аналізу літературних джерел, до 2005 р. присвячених частинкам та їх токсичності
 ВПЛИВ НАНОМАТЕРІАЛІВ НА ЗДОРОВ’Я ЛЮДИНИ • Наноматеріали, що виробляються, характеризуються токсичним ефектом, який не можна пояснити лише зменшенням розмірів (Lam et al. , 2004; Warheit et al. , 2004). • Слід брати до уваги не лише нанорозміри, але й форму, велику площу поверхні, заряд, високу реактивну здатність наноматеріалів (Sayes et al. , 2004; Cai et al. , 1992; Sclafani and Herrmann, 1996; Nemmar et al. , 2003; Derfus et al. , 2004). • Можлива участь принципово нових механізмів. Так, наприклад, є гіпотеза, що стверджує можливий вплив С 60 фулеренів на структуру, стабільність та біологічні функції ДНК (Zhao et al. , 2005).
ВПЛИВ НАНОМАТЕРІАЛІВ НА ЗДОРОВ’Я ЛЮДИНИ • Наноматеріали, що виробляються, характеризуються токсичним ефектом, який не можна пояснити лише зменшенням розмірів (Lam et al. , 2004; Warheit et al. , 2004). • Слід брати до уваги не лише нанорозміри, але й форму, велику площу поверхні, заряд, високу реактивну здатність наноматеріалів (Sayes et al. , 2004; Cai et al. , 1992; Sclafani and Herrmann, 1996; Nemmar et al. , 2003; Derfus et al. , 2004). • Можлива участь принципово нових механізмів. Так, наприклад, є гіпотеза, що стверджує можливий вплив С 60 фулеренів на структуру, стабільність та біологічні функції ДНК (Zhao et al. , 2005).
 Чим менша частинка, тим більший ризик!
Чим менша частинка, тим більший ризик!
 ВПЛИВ НАНОМАТЕРІАЛІВ НА НАВКОЛИШНЄ СЕРЕДОВИЩЕ • Можливо утворення побічних продуктів: так, застосування заліза нульової валентності до очищення ґрунту та ґрунтових вод від хлорованих забруднювачів (трихлороетилен, діхлороетилен) та важких металів супроводжується утворенням біфенілу та бензолу (Elliott et al. , 2005).
ВПЛИВ НАНОМАТЕРІАЛІВ НА НАВКОЛИШНЄ СЕРЕДОВИЩЕ • Можливо утворення побічних продуктів: так, застосування заліза нульової валентності до очищення ґрунту та ґрунтових вод від хлорованих забруднювачів (трихлороетилен, діхлороетилен) та важких металів супроводжується утворенням біфенілу та бензолу (Elliott et al. , 2005).
 ВПЛИВ НАНОМАТЕРІАЛІВ НА НАВКОЛИШНЄ СЕРЕДОВИЩЕ • Є дані, що свідчать про можливу пасивну дифузію наноматеріалів (розмірами від 0, 95 до 1, 5 нм) через мембрани зябер риб (Zitko, 1981; Opperhuizen et al. , 1985; Niimi and Oliver, 1988; Mc. Kim et al. , 1985).
ВПЛИВ НАНОМАТЕРІАЛІВ НА НАВКОЛИШНЄ СЕРЕДОВИЩЕ • Є дані, що свідчать про можливу пасивну дифузію наноматеріалів (розмірами від 0, 95 до 1, 5 нм) через мембрани зябер риб (Zitko, 1981; Opperhuizen et al. , 1985; Niimi and Oliver, 1988; Mc. Kim et al. , 1985).
 ВПЛИВ НАНОМАТЕРІАЛІВ НА НАВКОЛИШНЄ СЕРЕДОВИЩЕ • Наночастинки двоокису титану (10 -20 нм) викликають токсичний ефект у Daphnia magna за концентрацією 5, 5 ppm (Oberdörster, 2004), тоді як великі частинки діоксиду титану (що містяться у сонцезахисному кремі, у фарбі та зубній пасті) токсичних ефектів не викликають.
ВПЛИВ НАНОМАТЕРІАЛІВ НА НАВКОЛИШНЄ СЕРЕДОВИЩЕ • Наночастинки двоокису титану (10 -20 нм) викликають токсичний ефект у Daphnia magna за концентрацією 5, 5 ppm (Oberdörster, 2004), тоді як великі частинки діоксиду титану (що містяться у сонцезахисному кремі, у фарбі та зубній пасті) токсичних ефектів не викликають.
 Висновки • Нанотехнологія прогресує, але на сьогоднішній день даних щодо потенційної токсичної дії наноматеріалів на живі організми (людину, рослини, тварин, мікроорганізми) замало. • Потрібні подальші дослідження на основі застосування сучасних методів та приладів.
Висновки • Нанотехнологія прогресує, але на сьогоднішній день даних щодо потенційної токсичної дії наноматеріалів на живі організми (людину, рослини, тварин, мікроорганізми) замало. • Потрібні подальші дослідження на основі застосування сучасних методів та приладів.
 Bioleaching • The discovery that bacteria could 'mine' metals for us was made in Spain. The Rio Tinto mine, in the southwest corner of Spain, was originally mined for copper by the Romans some 2, 000 years ago. • In 1752, some mining engineers looked over the mine to see if it could be possibly re-opened. They noticed streams of a blue-green liquid running through tailings of the excavated rock that lay around the mine. • When this blue-green liquid ran over iron, it coated the iron with a brown film. The brown film (the same colour brown as the copper pipes in your house) was metallic copper. • But in 1947, US scientists discovered that the copper was being 'mined' by a bacteria called Theobacillus ferrooxidans
Bioleaching • The discovery that bacteria could 'mine' metals for us was made in Spain. The Rio Tinto mine, in the southwest corner of Spain, was originally mined for copper by the Romans some 2, 000 years ago. • In 1752, some mining engineers looked over the mine to see if it could be possibly re-opened. They noticed streams of a blue-green liquid running through tailings of the excavated rock that lay around the mine. • When this blue-green liquid ran over iron, it coated the iron with a brown film. The brown film (the same colour brown as the copper pipes in your house) was metallic copper. • But in 1947, US scientists discovered that the copper was being 'mined' by a bacteria called Theobacillus ferrooxidans
 Iron Bacteria • The dramatic effects of iron bacteria are seen in surface waters as brown slimy masses on stream bottoms and lakeshores. • More serious problems occur when bacteria build up in well systems. A burn in Scotland with Iron bacteria.
Iron Bacteria • The dramatic effects of iron bacteria are seen in surface waters as brown slimy masses on stream bottoms and lakeshores. • More serious problems occur when bacteria build up in well systems. A burn in Scotland with Iron bacteria.
 Iron-Eating Bacteria • One of these microorganisms, Geobacter metallireducens, has an unusual survival tactic for life in the underworld: It uses a sensor to 'sniff out' metals. If metal is not nearby, G. metallireducens can spontaneously grow flagella—whip-like cellular propellers—to find new energy sources.
Iron-Eating Bacteria • One of these microorganisms, Geobacter metallireducens, has an unusual survival tactic for life in the underworld: It uses a sensor to 'sniff out' metals. If metal is not nearby, G. metallireducens can spontaneously grow flagella—whip-like cellular propellers—to find new energy sources.
 Iron Bacteria • Iron bacteria are bacteria that derive the energy they need to live and multiply by oxidizing dissolved ferrous iron. sp. Thiobacillus sp.
Iron Bacteria • Iron bacteria are bacteria that derive the energy they need to live and multiply by oxidizing dissolved ferrous iron. sp. Thiobacillus sp.
Thiobacillus ferrooxidans • Commercial applications of bioleaching have been developed for the solution mining of copper and uranium from low-grade ores and waste products. Uranium minerals are often found associated with the mineral pyrite. Thiobacillus ferrooxidans is used to oxidize pyrite and release the uranium according to the reaction discussed above. The ferric sulfate and sulfuric acid generated in this reaction then dissolve the uranium. A colony of Thiobacillus ferrooxidans. The reddish color is the result of iron production.
Thiobacillus ferrooxidans • Commercial applications of bioleaching have been developed for the solution mining of copper and uranium from low-grade ores and waste products. Uranium minerals are often found associated with the mineral pyrite. Thiobacillus ferrooxidans is used to oxidize pyrite and release the uranium according to the reaction discussed above. The ferric sulfate and sulfuric acid generated in this reaction then dissolve the uranium. A colony of Thiobacillus ferrooxidans. The reddish color is the result of iron production.
 Gold in Nature Gold Nuggets found in Arizona High-grade gold ore from a quartz vein near Alma, Colorado
Gold in Nature Gold Nuggets found in Arizona High-grade gold ore from a quartz vein near Alma, Colorado
 The extraction of gold • The extraction of gold from its ore can involve numerous ferrous and sulfur oxidizing bacteria, including Acidithiobacillus ferrooxidans and Acidithiobacillus thiooxidans (formerly known as Thiobacillus). • Both of these bacteria are used in a mining technique called bioleaching whereby metals are extracted from their ores through oxidation
The extraction of gold • The extraction of gold from its ore can involve numerous ferrous and sulfur oxidizing bacteria, including Acidithiobacillus ferrooxidans and Acidithiobacillus thiooxidans (formerly known as Thiobacillus). • Both of these bacteria are used in a mining technique called bioleaching whereby metals are extracted from their ores through oxidation
 Bacteria Plant • The world's largest bacteria plant is planned for Wiluna in Western Australia. The bacteria are expected to process some 400, 000 tonnes of gold sulphide per year. Gold-mining has always used rather toxic chemicals to extract the gold. The bacteria should be cleaned.
Bacteria Plant • The world's largest bacteria plant is planned for Wiluna in Western Australia. The bacteria are expected to process some 400, 000 tonnes of gold sulphide per year. Gold-mining has always used rather toxic chemicals to extract the gold. The bacteria should be cleaned.
 Bioleaching • In bioremediation this process has been used to leach uranium from nuclear-wastecontaminated soils and to remove copper from copper tailings. • Bacterial surfactants can also be used for removal of metals from contaminated soils and water.
Bioleaching • In bioremediation this process has been used to leach uranium from nuclear-wastecontaminated soils and to remove copper from copper tailings. • Bacterial surfactants can also be used for removal of metals from contaminated soils and water.
 Bioleaching • Bioleaching is the extraction of specific metals from their ores through the use of bacteria. • Bioleaching is one of several applications within biohydrometallurgy and several methods are used to recover copper, zinc, lead, arsenic, nickel, molybdenum, gold, and cobalt. • Low concentrations are not a problem for bacteria because they simply ignore the waste which surrounds the metals, attaining extraction yields of over 90% in some cases.
Bioleaching • Bioleaching is the extraction of specific metals from their ores through the use of bacteria. • Bioleaching is one of several applications within biohydrometallurgy and several methods are used to recover copper, zinc, lead, arsenic, nickel, molybdenum, gold, and cobalt. • Low concentrations are not a problem for bacteria because they simply ignore the waste which surrounds the metals, attaining extraction yields of over 90% in some cases.
 Bioleaching with Fungi • Several species of fungi can be used for bioleaching. Experiments have shown that two fungal strains (Aspergillus Niger, Penicillium simplicissimum) were able to mobilize Cu and Sn by 65%, and Al, Ni, Pb, and Zn by more than 95%. • Aspergillus Niger can produce some organic acids such as citric acid. So it can be used for bioleaching sulfides.
Bioleaching with Fungi • Several species of fungi can be used for bioleaching. Experiments have shown that two fungal strains (Aspergillus Niger, Penicillium simplicissimum) were able to mobilize Cu and Sn by 65%, and Al, Ni, Pb, and Zn by more than 95%. • Aspergillus Niger can produce some organic acids such as citric acid. So it can be used for bioleaching sulfides.
 Fungi • Several species of fungi can be used for bioleaching. • Experiments have shown that two fungal strains (Aspergillus Niger, Penicillium simplicissimum) were able to mobilize Cu and Sn by 65%, and Al, Ni, Pb, and Zn by more than 95%. • Aspergillus Niger can produce some organic acids and it can be used for bioleaching sulfides.
Fungi • Several species of fungi can be used for bioleaching. • Experiments have shown that two fungal strains (Aspergillus Niger, Penicillium simplicissimum) were able to mobilize Cu and Sn by 65%, and Al, Ni, Pb, and Zn by more than 95%. • Aspergillus Niger can produce some organic acids and it can be used for bioleaching sulfides.
 Heavy Metals • Heavy metals are natural • However, at higher components of the Earth's concentrations they can crust. They cannot be lead to poisoning. Heavy degraded or destroyed. metal poisoning could To a small extent they result, for instance, from enter our bodies via food, drinking-water drinking water and air. As contamination (e. g. lead trace elements, some pipes), high ambient air heavy metals (e. g. concentrations near copper, selenium, zinc) emission sources, or are essential to maintain intake via the food chain. the metabolism of the Heavy metals are human body. dangerous because they tend to bioaccumulate.
Heavy Metals • Heavy metals are natural • However, at higher components of the Earth's concentrations they can crust. They cannot be lead to poisoning. Heavy degraded or destroyed. metal poisoning could To a small extent they result, for instance, from enter our bodies via food, drinking-water drinking water and air. As contamination (e. g. lead trace elements, some pipes), high ambient air heavy metals (e. g. concentrations near copper, selenium, zinc) emission sources, or are essential to maintain intake via the food chain. the metabolism of the Heavy metals are human body. dangerous because they tend to bioaccumulate.
 Microbial processes used in bioremediation
Microbial processes used in bioremediation
 Chromium • For example, Cr(III), an important micronutrient, is poorly soluble in water, but the oxidezed form Cr(VI) is highly water soluble and is a potent mutagen and carcinogen. • In trace amounts, chromium is considered an essential nutrient for numerous organisms, but at higher level, it is toxic and mutagenic.
Chromium • For example, Cr(III), an important micronutrient, is poorly soluble in water, but the oxidezed form Cr(VI) is highly water soluble and is a potent mutagen and carcinogen. • In trace amounts, chromium is considered an essential nutrient for numerous organisms, but at higher level, it is toxic and mutagenic.
 Chromium • In an attempt to evaluate the use of Cr-resistant • A number of Cr(VI)bacteria for the reducing microbial strains bioremediation of have been recently isolated from chromate • Cr (VI)-contaminated soils contaminated waters, researchers have isolated soils, and sediments, a population of P. such as Oscillatoria sp. , mendocina from a Arthrobacter sp. , sewage sludge and used Agrobacter sp. , it for the reduction of Cr Pseudomonas (VI) to Cr (III) in a soil aeruginosa S 128, microcosm study. Their Zooglea ramigera, and results indicate that P. algae: Chlamydomonas mendocina was able to sp. , Chlorella vulgaris. immobilize 100 mg kg‑ 1 Cr (VI) in 8 h by reducing it to Cr (III).
Chromium • In an attempt to evaluate the use of Cr-resistant • A number of Cr(VI)bacteria for the reducing microbial strains bioremediation of have been recently isolated from chromate • Cr (VI)-contaminated soils contaminated waters, researchers have isolated soils, and sediments, a population of P. such as Oscillatoria sp. , mendocina from a Arthrobacter sp. , sewage sludge and used Agrobacter sp. , it for the reduction of Cr Pseudomonas (VI) to Cr (III) in a soil aeruginosa S 128, microcosm study. Their Zooglea ramigera, and results indicate that P. algae: Chlamydomonas mendocina was able to sp. , Chlorella vulgaris. immobilize 100 mg kg‑ 1 Cr (VI) in 8 h by reducing it to Cr (III).
 Mercury • Mercury is a toxic substance which has no known function in human biochemistry or physiology and does not occur naturally in living organisms. • Such forms of mercury as monomethylmercury and dimethylmercury are highly toxic; these forms cause neurotoxicological disorders.
Mercury • Mercury is a toxic substance which has no known function in human biochemistry or physiology and does not occur naturally in living organisms. • Such forms of mercury as monomethylmercury and dimethylmercury are highly toxic; these forms cause neurotoxicological disorders.
 Microbial transformations of mercury • Microbial transformations • Microorganisms transform of mercury have been mercury between the long been of interest, ionic Hg(II) and elemental because they control the Hg(0) forms, convert production of the potent Hg(II) to CH 3 Hg and neurotoxin methylmercury degradate CH 3 Hg. (CH 3 Hg) in the environment. Very low concentrations of CH 3 Hg are bioaccumulated more than a million times in predatory fish.
Microbial transformations of mercury • Microbial transformations • Microorganisms transform of mercury have been mercury between the long been of interest, ionic Hg(II) and elemental because they control the Hg(0) forms, convert production of the potent Hg(II) to CH 3 Hg and neurotoxin methylmercury degradate CH 3 Hg. (CH 3 Hg) in the environment. Very low concentrations of CH 3 Hg are bioaccumulated more than a million times in predatory fish.
 Microbial methylation plays an important role, because methylated compounds are often volatile. Mercury, Hg(II) can be biomethylated by a number of different bacterial species such as Pseudomonas sp. , Escherichia sp. , Bacillus sp. , Clostridium sp. to gaseous methyl mercury – the most toxic and the most accumulated form of Hg.
Microbial methylation plays an important role, because methylated compounds are often volatile. Mercury, Hg(II) can be biomethylated by a number of different bacterial species such as Pseudomonas sp. , Escherichia sp. , Bacillus sp. , Clostridium sp. to gaseous methyl mercury – the most toxic and the most accumulated form of Hg.
 Minamata disease • Minamata disease (水俣病 Minamata-byō) is a neurological syndrome caused by severe mercury poisoning. • Symptoms include ataxia, numbness in the hands and feet, general muscle weakness, narrowing of the field of vision and damage to hearing and speech. • In extreme cases, insanity, paralysis, coma and death follow within weeks of the onset of symptoms. • Minamata disease was first discovered in Minamata city in Kumamoto prefecture, Japan in 1956. • It was caused by the release of methyl mecury in the industrial wastewaterr from the Chisso Corporation’s chemical factory, which continued from 1932 to 1968. • This highly toxic chemical bioaccumulated in shellfish and fish in Minamata Bay and the Shiranui Sea, which when eaten by the local populace resulted in mercury poisoning.
Minamata disease • Minamata disease (水俣病 Minamata-byō) is a neurological syndrome caused by severe mercury poisoning. • Symptoms include ataxia, numbness in the hands and feet, general muscle weakness, narrowing of the field of vision and damage to hearing and speech. • In extreme cases, insanity, paralysis, coma and death follow within weeks of the onset of symptoms. • Minamata disease was first discovered in Minamata city in Kumamoto prefecture, Japan in 1956. • It was caused by the release of methyl mecury in the industrial wastewaterr from the Chisso Corporation’s chemical factory, which continued from 1932 to 1968. • This highly toxic chemical bioaccumulated in shellfish and fish in Minamata Bay and the Shiranui Sea, which when eaten by the local populace resulted in mercury poisoning.
 Minamata disease Minamata Chisso Factory (red), Minamata River (blue) and reclaimed area in the Minamata Bay (green) Courtesy of Prof. Yugo ONO
Minamata disease Minamata Chisso Factory (red), Minamata River (blue) and reclaimed area in the Minamata Bay (green) Courtesy of Prof. Yugo ONO
 Minamata disease Discharge channel from Chisso factory • Environmetal standard : 0, 4 ppm • For a person (50 Kg weight): • If you continue to eat fish (600 g) of this standard only for 1 year, you will become • a patient of • Minamata Disease Courtesy of Prof. Yugo ONO
Minamata disease Discharge channel from Chisso factory • Environmetal standard : 0, 4 ppm • For a person (50 Kg weight): • If you continue to eat fish (600 g) of this standard only for 1 year, you will become • a patient of • Minamata Disease Courtesy of Prof. Yugo ONO
 1, 500 pictures of victims of Minamata Disease Courtesy of Prof. Yugo ONO
1, 500 pictures of victims of Minamata Disease Courtesy of Prof. Yugo ONO
 Lessons from Minamata • For Environmental issues related to the life, (not only human but also wildlife) Why the discharge of methyl mercury was not stopped? • Stop first, then analyze ! Courtesy of Prof. Yugo ONO
Lessons from Minamata • For Environmental issues related to the life, (not only human but also wildlife) Why the discharge of methyl mercury was not stopped? • Stop first, then analyze ! Courtesy of Prof. Yugo ONO
 Inductively coupled plasma mass spectrometry Мас-спектрометрія з індуктивно-зв’язаною плазмою (ІЗП-МС). • One techbique that is applicable to nearly all metals is Inductively coupled plasma mass spectrometry (ICP-MS). It is based on coupling together an inductevely coupled plasma as a method of producing ions with a mass spectrometer as a method of separating and detecting the ions. • The temperature of the plasma is very high, of the order of 10, 000 K.
Inductively coupled plasma mass spectrometry Мас-спектрометрія з індуктивно-зв’язаною плазмою (ІЗП-МС). • One techbique that is applicable to nearly all metals is Inductively coupled plasma mass spectrometry (ICP-MS). It is based on coupling together an inductevely coupled plasma as a method of producing ions with a mass spectrometer as a method of separating and detecting the ions. • The temperature of the plasma is very high, of the order of 10, 000 K.
 ICP-MS Samples are decomposed to neutral elements in a high temperature argon plasma and analyzed based on their mass to charge ratios. An ICP-MS can be thought of as four main processes, including sample introduction and aerosol generation, ionization by an argon plasma source, mass discrimination, and the detection system.
ICP-MS Samples are decomposed to neutral elements in a high temperature argon plasma and analyzed based on their mass to charge ratios. An ICP-MS can be thought of as four main processes, including sample introduction and aerosol generation, ionization by an argon plasma source, mass discrimination, and the detection system.
 ICP-MS • Inductively coupled plasma mass spectrometry (ICP-MS) is a type of mass spectrometry that is highly sensitive and capable of the determination of a range of metals at concentrations below one part in 1012 (part per trillion).
ICP-MS • Inductively coupled plasma mass spectrometry (ICP-MS) is a type of mass spectrometry that is highly sensitive and capable of the determination of a range of metals at concentrations below one part in 1012 (part per trillion).
 ICP-MS • An inductevely coupled plasman is a plasma that contains a sufficient concentration of ions and electrons to make the gas electrically conductive.
ICP-MS • An inductevely coupled plasman is a plasma that contains a sufficient concentration of ions and electrons to make the gas electrically conductive.
 ICP-MS • An inductively coupled plasma (ICP) for spectrometry is sustained in a torch that consists of three concentric tubes, usually made of quartz. The end of this torch is placed inside an induction coil supplied with a radio-frequency electric current.
ICP-MS • An inductively coupled plasma (ICP) for spectrometry is sustained in a torch that consists of three concentric tubes, usually made of quartz. The end of this torch is placed inside an induction coil supplied with a radio-frequency electric current.
 ICP-MS • A flow of argon gas is introduced between the two outermost tubes of the torch and an electrical spark is applied for a short time to introduce free electrons into the gas stream. • These electrons interact with the radio-frequency magnetic field of the induction coil and are accelerated first in one direction, then the other, as the field changes at high frequency.
ICP-MS • A flow of argon gas is introduced between the two outermost tubes of the torch and an electrical spark is applied for a short time to introduce free electrons into the gas stream. • These electrons interact with the radio-frequency magnetic field of the induction coil and are accelerated first in one direction, then the other, as the field changes at high frequency.
 ICP-MS
ICP-MS
 ICP-MS
ICP-MS
 CONCLUSIONS: BIOREMEDIATION • This technology • This technique has demonstrated ability failed to show efficient to remove results in removing halogenated and nonheavy metals from halogenated volatiles contaminated soils. and semi-volatiles, as well as pesticides.
CONCLUSIONS: BIOREMEDIATION • This technology • This technique has demonstrated ability failed to show efficient to remove results in removing halogenated and nonheavy metals from halogenated volatiles contaminated soils. and semi-volatiles, as well as pesticides.


